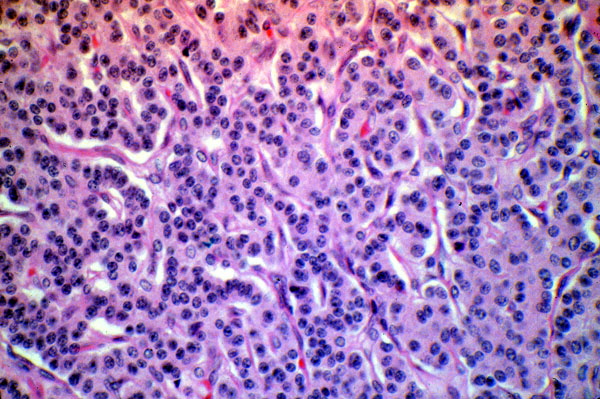

Carcinoid tumor
Click picture to enlarge. Close window to return
This is a microscopic example of a pulmonary carcinoid tumor. Carcinoid tumors may vary considerably in their microscopic appearance; this slide shows a common pattern composed of groups of bland appearing cells separated from adjacent groups by slender partitions of connective tissue containing thin walled blood vessels.